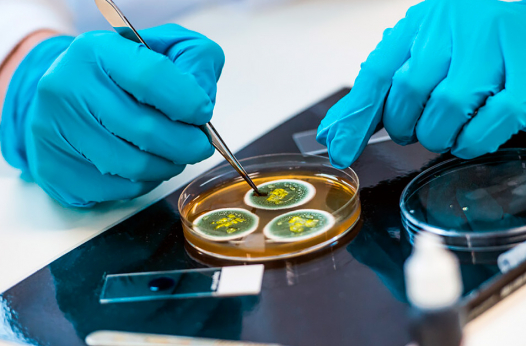

| Язык обучения: |
английский |
| Год основания: | 1891 |
| Тип программ: |
Высшее образование Бакалавриат Магистратура Докторантура |
Университет Суррея был основан в 1891 году. Фактически его преемником является Политехнический институт Баттерси. Первые студенты пришли в институт в 1894 году. Целью его создания было расширение возможностей получения высшего образования для малоимущих слоев населения. В начале ХХ века в Политехническом институте Баттерси преподавались химия, физика, электротехника, математика, музыка и иностранные языки. В 1956 году институт сменил название на Технический колледж Баттерси и начал переезд в Гилфорд. Статус университета ему удалось получить в 1966 году. В 2021 году он отмечает 55-летний юбилей в этом качестве.
Сегодня University of Surrey входит в «Группу 1994» - объединение из 19 университетов, ведущих активную исследовательскую деятельность. Также он является членом Ассоциации МВА, Ассоциации университетов Европы и Ассоциации Университетов Содружества. Он занимает 39-е место в рейтинге The Times и The Sunday Times и 54-е место в рейтинге The Guardian. В международном рейтинге университетов от The Times он занимает 263-е место и 272 – в QS World University Rankings. Университет находится на 1-м месте в Великобритании по преподаванию парамедицинских наук, на 2-м – по преподаванию науки о питании и социологии и на 6-м – по преподаванию предмета «Гостиничный бизнес и туризм». Качество преподавания также отмечено золотым призом Teaching Excellence Framework.
Среди известных выпускников университета – звукорежиссёр и лауреат премии «Оскар» Крис Бенстед, топ-менеджер сети отелей Hilton в Лондоне Элисон Пэйлин, президент корпорации Semtec Мохан Махесваран.
Университет предлагает своим студентам обучение по следующим специальностям: парамедицина, нутрициология, гостиничный бизнес и туризм, социология, инженерия. Карьерная служба университета завоевывает награду National University Employability Award уже третий год подряд. 96% выпускников Университета Суррея находят работу по окончании или продолжают развиваться в науке. Топ-5 отраслей, в которых работают выпускники, включают в себя образование, здравоохранение, инженерию, финансы и информатику. По изучению некоторых предметов рейтинг удовлетворенности студентов достигает 100%.
Руководство и преподаватели видят миссию университета в том, чтобы дать студентам отличное образование и способствовать распространению знаний. Его цели – изменение мира для создания лучшего будущего посредством сотрудничества со студентами, выпускниками и местными сообществами и оказание социального и экономического влияния при помощи инноваций и решения глобальных проблем. Стратегические цели University of Surrey – стать глобальным лидером в сфере высшего образования и ведущим исследовательским институтом.
University of Surrey материально поощряет наиболее талантливых студентов. Например, студентки, изучающие бизнес, могут рассчитывать на стипендию Women in Leadership. Кроме того, студенты, обучающееся на любом факультете могут пройти стажировку в одной из более чем 2300 британских и зарубежных компаний, среди которых Airbus, AstraZeneca, IBM, Toyota и многие другие.
В инфраструктуру университета входят учебные аудитории, лекционные залы и библиотека. Также учебному заведению принадлежит исследовательский центр и Космический центр Суррея, в котором изготавливаются космические спутники и оборудование для космических кораблей. В университете работает книжный магазин, почтовое отделение, кафе и рестораны.
Кампус университета располагается в городе Гилфорд (графство Суррей). Рядом с ним располагается одна из главных достопримечательностей города – Гилфордский собор. Недалеко находится тематический парк Air Hop Trampoline и театральное училище.
Преимущества обучения в University of Surrey:
- высокие места в мировых и британских рейтингах - 39-е место в рейтинге The Times и The Sunday Times и 272-е – в QS World University Rankings;
- высокий уровень преподавания, подтвержденный 1-м местом по преподаванию парамедицины и 2-м - по преподаванию науки о питании и социологии;
- сильный преподавательский состав, удостоенный золотой награды Teaching Excellence Framework;
- уровень удовлетворенности студентов достигает 100%;
- уровень трудоустройства выпускников составляет 96%;
- возможность пройти стажировку в крупной компании с мировым именем
Сроки подачи документов:
сентябрь
51.2431429, -0.5894664
Подготовительная программа International Foundation
- Заполненная анкета;
- Копия паспорта;
- Аттестат о среднем образовании;
- Сертификат, подтверждающий знание английского языка: IELTS не ниже 6.0, TOEFL не ниже 88
Бакалавриат
- Заполненная анкета;
- Копия паспорта;
- Аттестат о среднем образовании/диплом университета
- Сертификат об окончании Foundation Program;
- Сертификат, подтверждающий знание английского языка: IELTS не ниже 6.5,TOEFL не ниже 88
Магистратура
- Заполненная анкета;
- Копия паспорта;
- Диплом об окончании бакалавриата;
- Сертификат, подтверждающий знание английского: IELTS не ниже 6.5, TOEFL не ниже 88
Докторантура
- Заполненная анкета;
- Копия паспорта;
- Диплом об окончании бакалавриата;
- Диплом об окончании магистратуры;
- Эссе;
- Предложение исследования;
- Сертификат, подтверждающие знание английского: IELTS не ниже 6.5, TOEFL не ниже 88
Студенческая жизнь – это не только лекции и семинары, но и активное знакомство с культурой и образом жизни города и страны. Более того, студенты Университета Суррея активно общаются с представителями различных культур. Они посещают культурные мероприятия и собрания клубов по интересам, а также активно занимаются спортом.
После зачисления студент автоматически вступает в Студенческий союз University of Surrey. Он может выбрать то, что ему интересно от традиционных видов спорта до сообществ любителей самых необычных видов современного искусства.
Спорт
|
|



Танцы:
- Спортивные танцы;
- Бальные танцы;
- Сальса и бачата
Студенческие СМИ:
- Журнал The Stag;
- Телеканал StagTV;
- Радиостанция Stag Radio
Искусство:
- Аниме и манга;
- Мультипликация студии Disney;
- Джаз-оркестр;
- Киноклуб;
- Фотография;
- Театральный клуб
Стоимость обучения 2026
| Программа | Стоимость 1 года, £ |
|---|---|
| Подготовительная программа International Foundation | от 18500 |
| Бакалавриат | от 23800 |
| Магистратура | от 23800 |
| Докторантура | от 21800 |
Стоимость жилья 2026
| Тип проживания | Стоимость за академический год, £ |
|---|---|
| Резиденция | 10200 |
Дополнительно оплачивается (опционально)
- Авиаперелет;
- Медицинская страховка;
- Проживание и питание;
- Визовый сбор;
- Консульский сбор;
- Личные расходы.